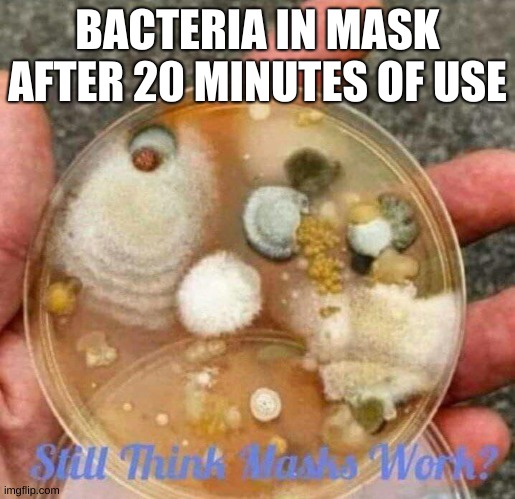

So many memes I threw in some boobs to help you through them all . . .































That was quite a ride, wasn’t it? – Glad to see you made it to the end . . .

Have Fun! – Run the Gun! – and remember – Fish Heads are Cheap!!
So many memes I threw in some boobs to help you through them all . . .

That was quite a ride, wasn’t it? – Glad to see you made it to the end . . .

Have Fun! – Run the Gun! – and remember – Fish Heads are Cheap!!